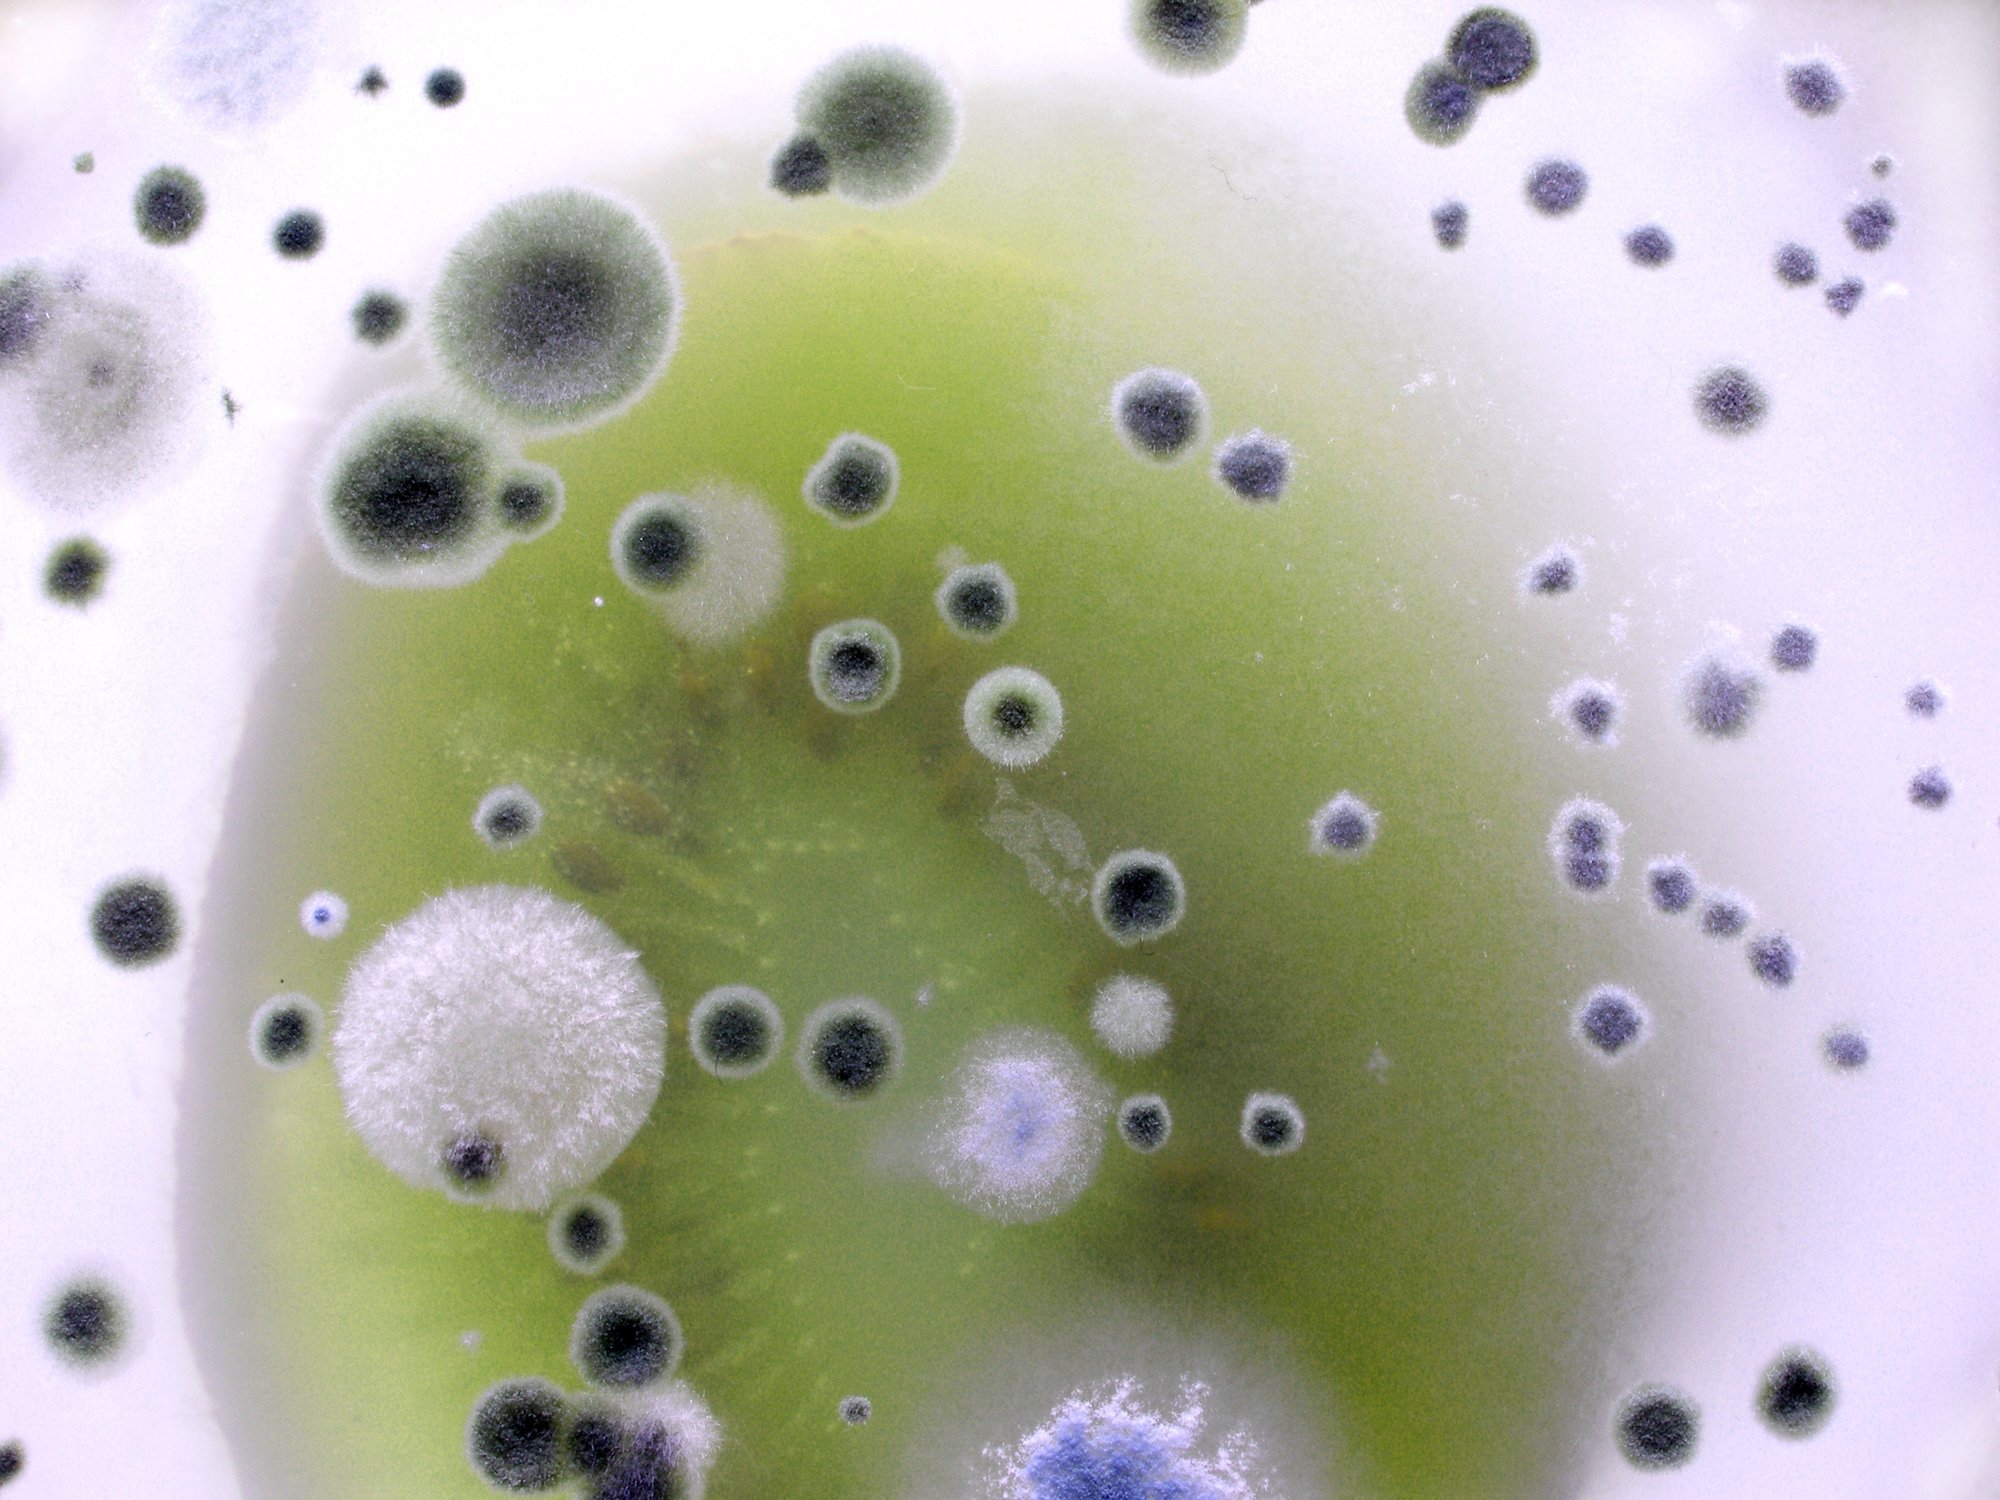
Moho en el vidrio.

Lidiar con la acumulación de moho nunca es divertido, pero deshacerse de esta plaga es importante para la salud general de su casa. Si bien hay muchos limpiadores en el mercado que eliminan el moho, existen soluciones más naturales para que sus superficies vuelvan a su estado original. Aquí hay una guía rápida sobre cómo eliminar el moho en su casa.
¿Cómo crece el moho?
El tipo de moho que causa el moho requiere humedad para crecer. El mildiú generalmente se cultiva durante el clima húmedo y es común en hogares cerrados. Una vez que el moho se adhiere, puede crear daños importantes en las superficies del hogar. Esto incluye materiales podridos y decolorarlos. En los edificios nuevos, el moho es común debido al alto contenido de humedad en los materiales.
¿Dónde crece el moho?
El moho crecerá en cualquier lugar donde pueda encontrar comida. Se encuentra más comúnmente en ropa de cama, algodón, seda, lana, cuero, papel, madera y rayón. Muchos materiales sintéticos resisten naturalmente el moho porque no retienen la humedad. En el hogar, es muy probable que encuentre crecimiento de moho en sótanos, espacios de acceso, baños y cocinas. Una vez que detecte el moho, debe actuar lo más rápido posible para evitar que se propague a otras superficies.
¿Cómo se elimina el moho?
Debe abstenerse de usar blanqueador con cloro para eliminar el moho de una superficie. Estos productos químicos son dañinos para los seres humanos y el medio ambiente. Solo debe usar productos químicos a base de cloro si el problema del moho es grave. Si ese es el caso, entonces probablemente sea mejor llamar a los profesionales para manejar la situación. Si bien los químicos de cloro están fuera de la mesa, existen muchas opciones naturales que puede usar para eliminar el moho de su hogar.
Eliminación de moho: vinagre blanco y bicarbonato de sodio

Puede eliminar la mayoría de las infestaciones de moho con un poco de vinagre blanco, bicarbonato de sodio y una esponja. Antes de comenzar, póngase unos guantes de limpieza para protegerse las manos de las bacterias del moho y una máscara. Es peligroso inhalar los olores del moho durante el proceso de limpieza. El vinagre en la mezcla matará el moho y los gérmenes que lo acompañan mientras elimina el mal olor que generalmente se asocia con el moho. Mientras tanto, el bicarbonato de sodio eliminará las manchas.
Aplicación de vinagre
Comience rociando vinagre blanco sin diluir directamente sobre el moho. No dude en cubrir el moho por completo con vinagre. Después de rociar el vinagre, déjelo que penetre en la superficie del moho y lo mate. Este proceso suele tardar unas horas. Puede volver a aplicar el vinagre si siente que no ha eliminado el moho.
Agregar bicarbonato de sodio

Una vez que el vinagre haya eliminado el moho, es hora de limpiarlo todo con un poco de bicarbonato de sodio. Vierta generosamente bicarbonato de sodio sobre la superficie del moho y use una esponja húmeda para restregar todo. Sigue fregando el moho hasta que desaparezca por completo y la superficie vuelva a la normalidad. Dependiendo de qué tan grave sea la infestación de moho, esto puede tomar bastante tiempo para terminar.
Peróxido de hidrógeno
Para el moho particularmente rebelde, vierta peróxido de hidrógeno concentrado en una botella rociadora y úselo para empapar la superficie afectada por el moho. Deje actuar su magia durante 10 a 20 minutos, luego frote la superficie con una esponja, enjuague bien con agua y seque.
Cuándo buscar ayuda
Si el moho se ha extendido a más de 10 pies cuadrados, debe buscar ayuda de profesionales. Los limpiadores de moho profesionales usarán productos químicos especiales para eliminar el moho y proteger la casa de una futura infestación. Como referencia futura, puede usar vinagre y bicarbonato de sodio para limpiar las superficies del hogar con regularidad.
Consejos para lidiar con el moho
Si el moho no se desprende de la superficie, puede considerar desechar el material y comenzar desde cero. Esto es especialmente común cuando se trata de materiales que son extra porosos o absorbentes. Cuando elimine el moho de una superficie, nunca debe pintar sobre ella en lugar de limpiarla. El moho eventualmente regresará a la superficie y seguirá propagándose. Es posible que no vea el crecimiento al principio, pero aún así será necesario eliminarlo correctamente.
